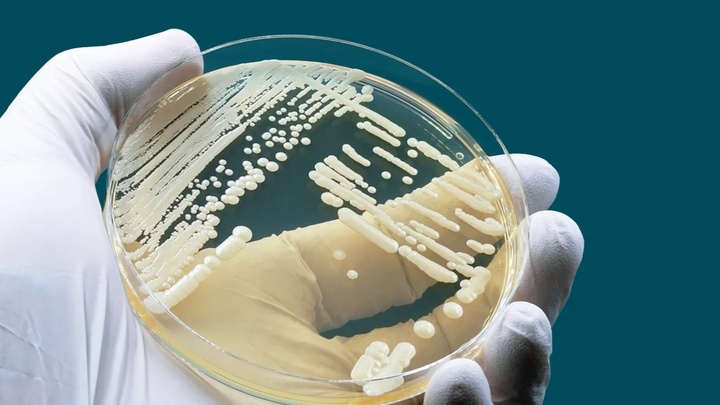
ZgotmplZ

Güney Kıbrıs'ta ölümcül mantar "candida auris" endişesi
15 Eylül 2025
Güncelleme: 15 Eylül 2025
Rum Sağlık Bakanlığı, Avrupa'da hastanelerde yayılan ve Güney Kıbrıs'ta da görülen, ilaçlara dirençli ve öldürücü olan bir mantar türüne karşı hastanelere, önleme ve kontrolü prosedürü içeren yönerge gönderdi.
Avrupa'da yayılan, çoklu antifungal ilaçlara dirençli maya türü “candida auris”in Güney Kıbrıs’ta da görüldüğü bildirildi.
Hastaneler gibi sağlık kuruluşlarında yayılabilen "candida auris", bağışıklık sistemi zayıf kişilerde ciddi hastalıklara neden olabiliyor.
Candida Auris, maya olarak büyüyen bir tür mantardır. Asklı mantarlar şubesinin üyesidirler. İnsanlarda enfeksiyona neden olan candida türlerindendir. Candida Auris yüksek salgın potansiyeline sahiptir ve halihazırda birçok hastane salgınına neden olmuştur.
Haberi “Ölümcül Mantar… Avrupa’da Yayılmasıyla İlgili Alarm-Kıbrıs’taki Durum” başlığıyla aktaran Alithia, Avrupa Hastalık Önleme ve Kontrol Merkezi’nin (ECDC) yayımladığı, Avrupa’da “candida auris” mantarı yayılımıyla ilgili son verilerin AB hastanelerinde endişe yarattığını, 2013-2023 dönemindeki vaka sayısının 4 bini aştığını kaydetti.
Habere göre Mikrobiyolog ve Epidemiyolojik Gözetim Merkezi üyesi Mihalis Mendris “OMEGA Channel”a yaptığı açıklamada, ECDC’nin son raporunda bu mantarın İspanya ve Yunanistan başta olmak üzere İtalya, Romanya ve Almanya’daki hastanelerde yaygın görüldüğüne işaret etti.

Aynı dönemde Güney Kıbrıs’ta kaydedilen vaka sayısının 13’e ulaştığına işaret eden Mendris görüldüğünü 2023 sonrası dönemde bazı münferit vakalar görüldüğünü söyledi ancak rakam vermedi. Mendris mantarın kolay tespit edilemediğine, ilaçlara karşı dirençli olduğuna, yüzde 30-70 öldürücülüğe sahip olduğuna dikkat çekti.
"BAKANLIK HASTANELERE YÖNERGE GÖNDERDİ"
Hastane ortamlarında ve yoğun bakım gibi birimlerde uzun süre yatılı kalan veya vücudunda tıbbi cihaz bulunan insanlarda yerleştiği için temizlenmesinin de çok zor olduğuna işaret eden Mendris, Rum Sağlık Bakanlığı’nın son dönemde hastanelere, “candida auris” mantarının önlenmesi ve kontrolü ile ilgili bir dizi prosedür içeren bir yönerge gönderdiğini de söyledi.
İLGİNİZİ ÇEKEBİLİR
Bizi Facebook'ta takip edin!
mykibris.com'u Facebook üzerinden takip edin, son paylaşımlardan haberdar olun.































Yorum Yap
Yorum yapabilmek için giriş yapmanız gerekmektedir.Giriş yapmak için tıklayınız.
Tüm Yorumlar